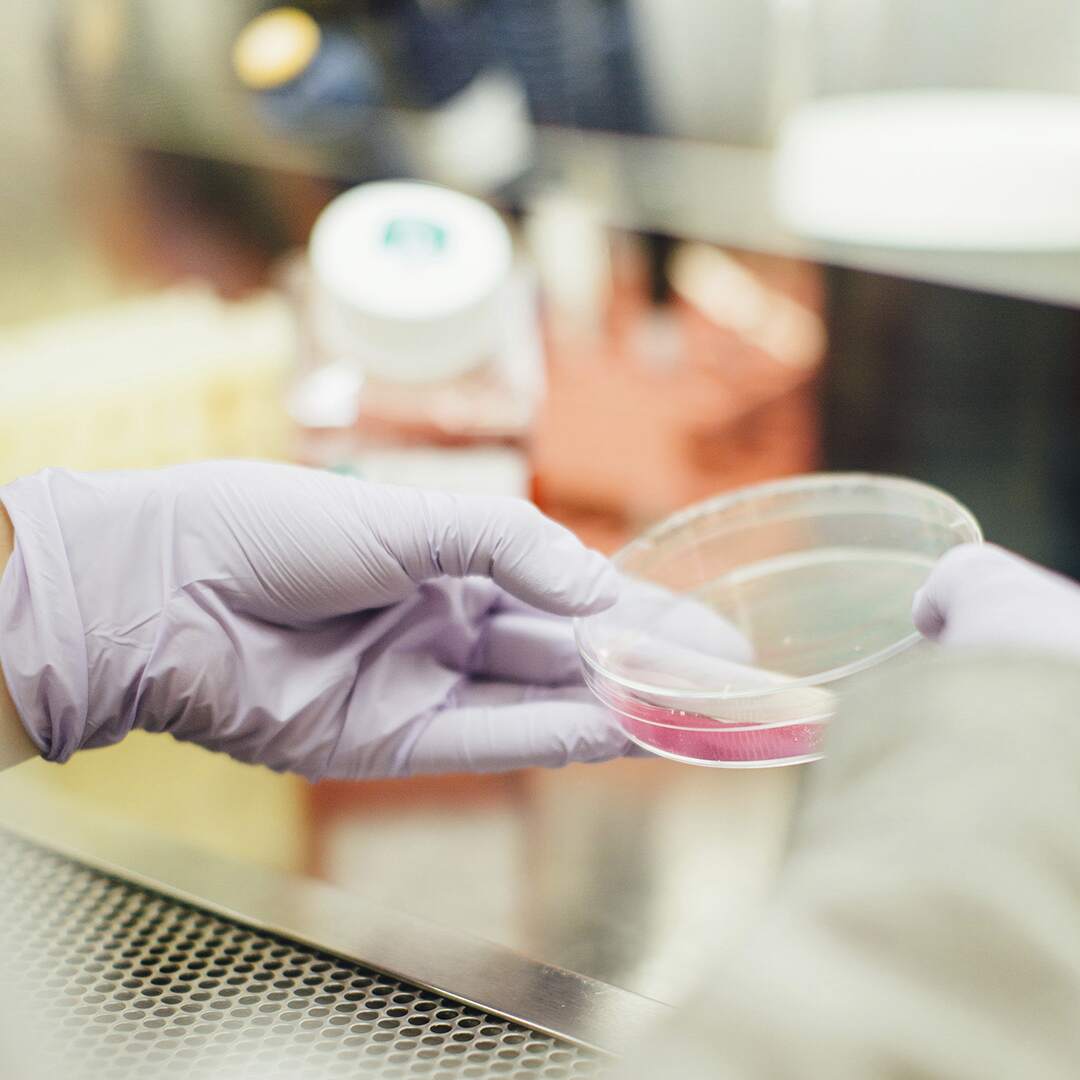

Nuestro Equipo
Somos personas del área de las ciencias biológicas, compuesto con profesionales de alta calidad que se han dedicado al estudio e investigación de procesos biológicos. Nuestro equipo está liderado por Biólogos, Bioquímicos, Ingenieros en biotecnología y otras carreras relacionadas con la ciencia.